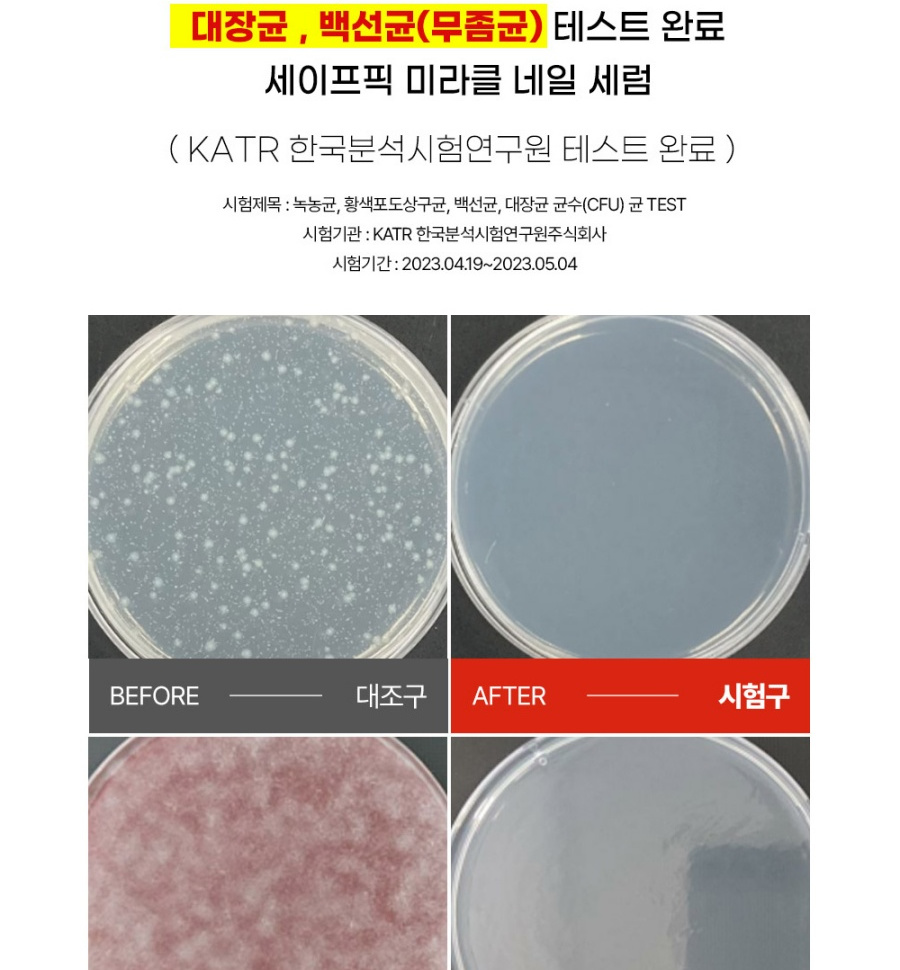

{{ 'fb_in_app_browser_popup.desc' | translate }} {{ 'fb_in_app_browser_popup.copy_link' | translate }}
{{ 'in_app_browser_popup.desc' | translate }}
新會員:$20購物金+首單95折(優惠代碼WELCOME) 暫不適用於『代購』『快閃』『清貨』三類貨品
全店,全店,買滿$600免港澳區順豐運費
商品存貨不足,未能加入購物車
您所填寫的商品數量超過庫存
{{'products.quick_cart.out_of_number_hint'| translate}}
{{'product.preorder_limit.hint'| translate}}
每筆訂單限購 {{ product.max_order_quantity }} 件
現庫存只剩下 {{ quantityOfStock }} 件
:產品介紹:
-爛甲救星, 有效改善香港腳、灰甲、受損指甲,提供手指甲和腳趾甲的瞬效營養修護
泡沫式清潔,已通過韓國KATR測試有效去除綠膿杆菌、金黃色葡萄球菌、大腸杆菌及發癬菌
-有效改善變厚的指甲、灰甲等,幫助集中的衛生管理及營養護理
-含有滋養手腳甲的專利成分及角蛋白,有助保濕、保護角質層及增強指甲的強度和光澤度
-已通過肌膚刺激測試
:使用方法:
1.先清洗或擦拭需要管理的指甲
2.需要管理的指甲較厚時,可先用指甲挫打磨指甲表面以使後續使用產品的效果更顯著
3.每天1~2次,取適量均勻塗抹於手腳指甲邊緣
4.泡沫消失後不用擦拭,直到被充分吸收後自然晾乾即可